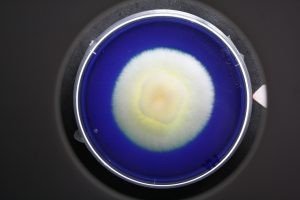

Der teilweise unsachgemäße und sorglose Gebrauch von Antibiotika trägt dazu bei, dass immer mehr Resistenzen entstehen und die Medikamente nicht mehr wirken, wenn sie benötigt werden. Dann zeigt ein Antibiotikum, das normalerweise das Wachstum einer bestimmten Bakterienart unterbinden würde, keine Wirkung mehr.
Dazu kommt, dass Antibiotika nicht nur bei der Behandlung bakterieller Infektionen eingesetzt werden, sie kommen auch in der Viehzucht zum Einsatz: zur Behandlung, zur Krankheitsprävention und – neben Hormonen – auch zur Wachstumsförderung. Die Folge ist, dass diese Hormone und Antibiotika und die Schmerzmittel und anderen chemischen Substanzen, die wir Menschen zu uns nehmen und unseren Tieren geben, irgendwann im Abwasser und somit auch wieder in der Wasserversorgung landen.
Wissenschaftler der TU Dresden arbeiten deshalb seit 2017 an einem Biofiltersystem auf der Basis von Pilzenzymen, das derartige chemische Rückstände effektiv und nachhaltig aus gereinigtem Abwasser entfernen soll. „Fremdbiologische Substanzen“, sogenannte Xenobiotika, wie Hormone, Schmerzmittel, Antibiotika, aber auch Röntgenkontrastmittel oder Industrie- und Agrarchemikalien, gelangen über das Abwasser in die Stoffkreisläufe der Natur. Laut Informationen der TU Dresden fließen allein in Deutschland jährlich etwa 300.000 Tonnen Mikroschadstoffe in die Wasserkreisläufe. Einige dieser Stoffe haben bereits in sehr geringer Konzentration nachteilige Wirkungen auf unser Ökosystem und unser Trinkwasser.
Die bestehenden dreistufigen kommunalen Wasser- und Abwasserreinigungsanlagen sind nur teilweise in der Lage, diese Schadstoffe herauszufiltern
Selbst modernste Anlagen könnten keine vollständige Reinigung leisten, umreißt die Projektleiterin Dr. Anett Werner das Problem. „Manche Mikroschadstoffe wie zum Beispiel Anti-Epileptika können bisher überhaupt nicht rausgefiltert werden. Über das Wasser gelangen sie in die Umwelt und verändern Fische und alle anderen lebenden Organismen.“ Noch gibt es für diese Stoffe keine gesetzlichen Grenzwerte, „doch das wird sich ändern müssen. Dann steht in vielen Klärwerken in Deutschland der Ausbau einer vierten Reinigungsstufe an. In der Schweiz ist das an vielen Stellen schon erfolgt.“
Dieses Biofiltersystem, das die Wissenschaftler entwickeln, funktioniert auf der Basis von bestimmten Pilzenzymen und soll die chemischen Verbindungen der naturfremden Rückstände aufspalten können. Den dafür nötigen Enzym-Cocktail besitzen allerdings nur Ständerpilze (Basidiomyceten). „Sie können ringförmige chemische Verbindungen, wie sie auch die kritischen Xenobiotika besitzen, aufspalten und schließlich zu deren Entfernung beitragen“, sagen die Forscher.

Pilze, deren Enzyme wie chemische Scheren arbeiten
„Wir wollen ein Filtersystem entwickeln, das zumindest einen Teil der Mikroschadstoffe auf natürlichem Weg entfernt. Dabei helfen uns Pilze, deren Enzyme wie chemische Scheren arbeiten“, so Werner. „Die Scheren zerschneiden die Ringstrukturen der Medikamente, dadurch werden sie biologisch abbaubar. Wir isolieren die Enzyme, binden sie an hochporöse metallische Werkstoffe und bauen sie in Filter am Ende der Kläranlagen ein. Sobald die Enzyme nicht mehr arbeiten, werden die Kugeln entnommen, erhitzt und mit neuen Enzymen versehen.“
Für das eigentliche Biofiltersystem mussten sie eine Technologie zur Immobilisierung (Isolation & Fixierung) der Enzyme auf hochporöse Träger konstruieren, erklären die Wissenschaftler. Als Trägermaterial wurden metallische Hohlkugeln aus einem Sintermaterial getestet, die kaum 4 Millimeter groß sind, Metallschäume, Membranen und Luffa-Schwämme. Diese Schwämme sind als Naturstoff reichlich und günstig verfügbar und können nach der Nutzung im Filter auch noch biologisch abgebaut werden kann. „Die Fixierung auf einem Träger ist wichtig, damit die Enzyme in einem Filtersystem an Ort und Stelle arbeiten können.“
Vielversprechende Laborversuche
Bei Versuchen im Labor hat sich gezeigt, dass die Enzyme auf metallischen Hohlkugeln selbst nach acht Wochen noch aktiv sind. Diesen Zeitraum wollen die Forscher aber noch weiter optimieren. Der Abbau der kritischen Substanzen in einer Biofilteranlage dauerte zwischen zwei und acht Stunden. Außerdem gelang es den Wissenschaftlern, 15 Substanzen – darunter Antibiotika, Schmerzmittel, Blutdrucksenker, Entwässerungsmittel und ein Anti-Epileptikum, für das es bisher keine praktikable technische Lösung gab – mithilfe der Pilzenzyme auf natürlichem Weg aus dem Wasser zu entfernen.
Dieses Verfahren der TU Dresden ist ein großer Schritt zur nachhaltigen Wassernutzung, denn das neue Biofiltersystem soll schon bald unter Realbedingungen getestet werden. In Zukunft soll das Verfahren auch für weitere Xenobiotika, wie verschiedene Antibiotika und Pestizide und auch Bisphenol-A, eine Industriechemikalie, die in der Plastikherstellung verwendet wird, optimiert werden.
Im Projekt XenoKat arbeiten unter der Leitung des Institutes für Naturstofftechnik an der TU Dresden die ASA Spezialenzyme GmbH, die BfG Bundesanstalt für Gewässerkunde sowie das CIMTT Zentrum für Produktionstechnik und Organisation der TU Dresden zusammen. Das Gesamtprojekt wird mit 700.000 Euro für den Zeitraum Mai 2017 bis Oktober 2019 vom Bundesministerium für Bildung und Forschung gefördert.
Zum Thema:
Mikroplastik in Süßgewässern und alpinen Flüssen
Ein DNA-Schnelltest vereinfacht die Bewertung der Wasserqualität




